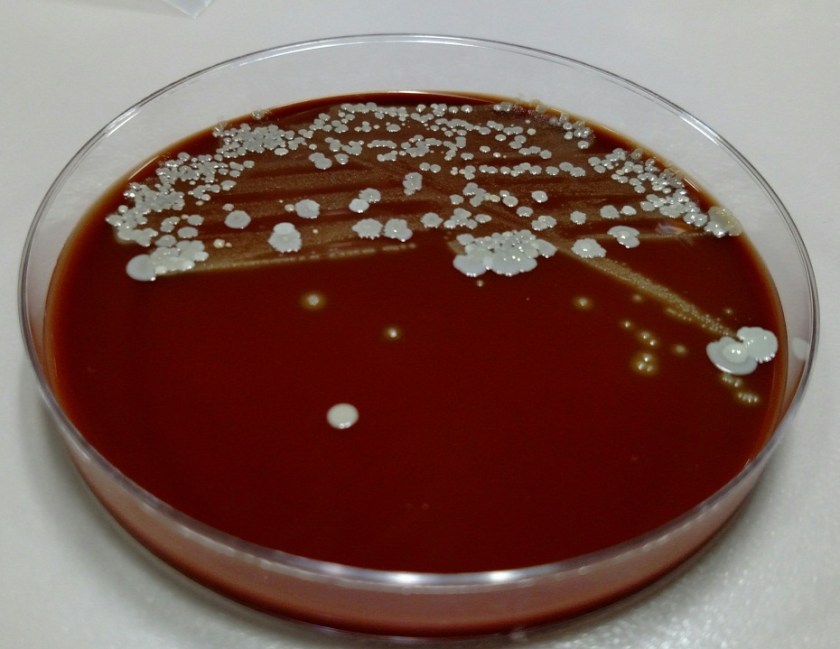
gang3

Case History:
A 72 year old man had been complaining of many months of constipation followed by several months of severe diarrhea prior to admission. He did not receive medical care for these symptoms and had no medical history on file. He presented to an outside hospital unresponsive, and an emergent CT showed subcutaneous emphysema and stranding of the lower abdominal tissue extending to the left hemiscrotum. Also noted was irregular wall thickening in the distal rectum. Of note, his family reported that the patient had hit his left scrotum with a power cord recoil a few days prior to presentation. He was transferred to our hospital, where the surgical team reported severe cellulitis and necrosis of the scrotum, perineum, anterior abdominal wall, and upper thighs. Due to his poor prognosis, the family decided to transition his care to comfort measures only and he passed away several hours after presentation. An autopsy was performed, which revealed liquefaction of the subcutaneous tissue in the lower anterior abdominal wall, dusky gray connective tissue of the left testis as well as a small abscess at the superior pole, and a circumferential distal rectal mass.
Laboratory Investigation:
A gram stain of the scrotal abscess and tissue of the anterior abdominal wall both showed mixed gram positive and gram negative organisms. Cultures of these specimens both grew mixed gram positives including alpha hemolytic Streptococcus and coagulase negative Staphylococcus, as well as mixed anaerobes including Bacteroides fragilis group.

Discussion:
The case above represents an example of Fournier’s gangrene, a necrotizing infection of the external genitalia and/or perineum. These infections are most often polymicrobial and often include organisms that would not be particularly aggressive by themselves, suggesting a synergy between anaerobic and aerobic organisms. In a large literature review of over 4,000 cases of Fournier’s gangrene, the most common pathogens involved were Escherichia coli, Streptococcus, Bacteroides, Enterobacter, and Staphylococcus. Our case fits well with this profile, consisting of a mixture of gram positives and gram negatives including Streptococcus, Staphylococcus, and Bacteroides fragilis group. Antibiotic coverage in these cases must be broad spectrum and include coverage for aerobes, anaerobes, gram negative and gram positive organisms.
Risk factors for Fournier’s gangrene include diabetes mellitus, smoking, alcoholism, renal failure, hypertension, and coronary artery disease. It is unclear whether the patient in this case had any of these risk factors as he did not routinely seek medical care.
The rectal mass in this case proved to be adenocarcinoma. There have been multiple case reports of Fournier’s gangrene in association with rectal cancer. The theory behind the mechanism of this association is that perforation of the rectal cancer occurs with tumor infiltration of surrounding tissues spreading infectious organisms. It is possible that our case was caused by the patient’s rectal cancer, but it is also possible that the rectal cancer was simply coincidental. The recent trauma to the patient’s scrotum could also have acted as a vector for infection.
The patient in our case presented too late in the course of his disease to receive appropriate treatment, which would consist of broad spectrum antibiotic administration and aggressive debridement. Even with such treatment, the mortality rate of Fournier’s gangrene is quite high, ranging from 5% to 40% in different case series.
References:
Bjurlin MA et al. Causative pathogens, antibiotic sensitivity, resistance patterns, and severity in a contemporary series of Fournier’s gangrene. Urology 2013;81(4):752-8.
Bruketa T et al. Rectal cancer and Fournier’s gangrene – current knowledge and therapeutic options. World J Gastroenterol 2015;21(30):9002-9020.
-Laurie Griesinger is a Pathology Student Fellow at University of Vermont Medical Center.

-Christi Wojewoda, MD, is the Director of Clinical Microbiology at the University of Vermont Medical Center and an Assistant Professor at the University of Vermont.